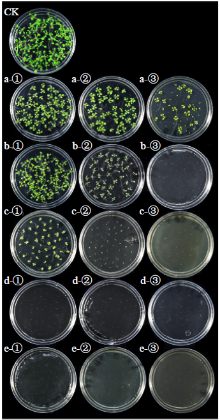
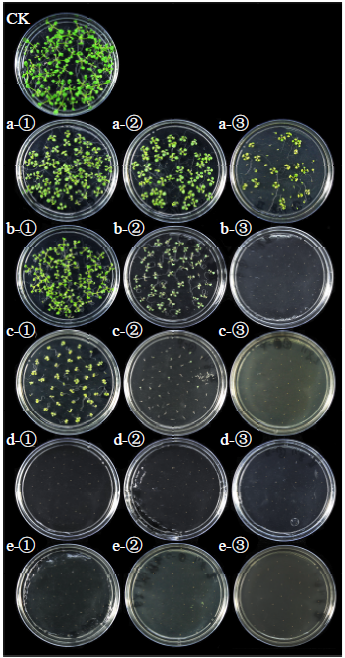

作物杂志,2023, 第4期: 245–252 doi: 10.16035/j.issn.1001-7283.2023.04.035
金荞不同器官提取物对几种杂草种子萌发的影响及其安全性研究
欧阳屹南1,2( ), 刘洋3, 沈伦豪1,2, 任奎1,2, 赵辉2, 唐新科1(
), 刘洋3, 沈伦豪1,2, 任奎1,2, 赵辉2, 唐新科1( ), 周美亮1,2(
), 周美亮1,2( )
)
- 1湖南科技大学生命科学与健康学院,411201,湖南湘潭
2中国农业科学院作物科学研究所,100081,北京
3西南大学农业与生物科技学院,400715,重庆
The Effects of Extracts from Different Organs of Fagopyrum cymosum on Seed Germination of Several Weeds and Its Safety to Crops
Ouyang Yinan1,2( ), Liu Yang3, Shen Lunhao1,2, Ren Kui1,2, Zhao Hui2, Tang Xinke1(
), Liu Yang3, Shen Lunhao1,2, Ren Kui1,2, Zhao Hui2, Tang Xinke1( ), Zhou Meiliang1,2(
), Zhou Meiliang1,2( )
)
- 1College of Life and Health Science, Hunan University of Science and Technology, Xiangtan 411201, Hunan, China
2Institute of Crop Sciences, Chinese Academy of Agricultural Sciences, Beijing 100081, China
3College of Agronomy and Biotechnology, Southwest University, Chongqing 400715, China
摘要:
通过考察不同溶剂及金荞提取物对拟南芥种子萌发的影响,分析了几种有机溶剂作为金荞化感物质提取溶剂的可行性,并研究了金荞不同器官提取物对杂草种子萌发和除草安全性的影响。结果表明,金荞茎5%甲醇提取物能明显抑制黑麦草和羊茅种子的萌发,化感效应指数分别为-0.35和-0.33,可作为两者除草剂的研究材料;金荞提取物对甜荞、苦荞、燕麦和小麦种子萌发没有显著影响,在生产实践中可作为这4种作物的生物除草材料;金荞提取物对大麦种子萌发影响较大,不宜在大麦生产中作为生物除草材料。
| [1] | 桂浩然, 王建, 董雄德, 等. 不同秸秆还田对冬闲期农田杂草多样性的影响. 农业环境科学学报, 2022, 41(4):746-754. |
| [2] | 蔡傅红, 曲润波, 王耀强, 等. 水稻秸秆提取物对几种杂草的抑制效果及其安全性研究. 现代农业科技, 2019(5):91-93. |
| [3] | 朱玉芹, 岳玉兰. 玉米秸秆还田培肥地力研究综述. 玉米科学, 2004, 12(3):106-108. |
| [4] |
Kong C H, Xuan T D, Khanh T D, et al. Allelochemicals and signaling chemicals in plants. Molecules, 2019, 24(15):2737.
doi: 10.3390/molecules24152737 |
| [5] | 罗晓玲, 熊仿秋, 钟林, 等. 密度对荞麦地杂草控制及对产量影响的研究. 西昌学院学报(自然科学版), 2016, 30(2):11-13. |
| [6] | 李春花, 孙道旺, 何成兴, 等. 荞麦秸秆粉还田对杂草及苦荞产量的影响. 杂草学报, 2017, 35(2):61-66. |
| [7] | 石旭旭, 王红春, 高婷, 等. 化感作用及其在杂草防除中的应用. 杂草科学, 2013, 31(2):6-9. |
| [8] | 谢媛怡, 陈丽娜, 花敏瑞, 等. 3种恶性杂草对荞麦化感潜力的比较研究. 四川师范大学学报(自然科学版), 2021, 44(6):822-828. |
| [9] | 杨媛, 杨蒲晨, 王慧. 荞麦杂草防控技术. 农业科技通讯, 2019 (8):278-280. |
| [10] | Zhou M L, Tang Y, Deng X, et al. Perennial self-incompatible wild Fagopyrum species//Buckwheat Germplasm in the World. London: Elsevier Press, 2018:61-66. |
| [11] |
商振达, 谭占坤, 李家奎, 等. 西藏地区荞麦与玉米混合青贮对发酵品质和微生物多样性的影响. 草业学报, 2019, 28(4):95-105.
doi: 10.11686/cyxb2018676 |
| [12] | 刘洋, 尚雪, 生膨菲, 等. 荞麦作物传统加工过程中的花粉散布及其农业考古应用. 中国科学:地球科学, 2019, 49(3):584-595. |
| [13] | 张文, 赵丽芬, 邓蓉. 野生金荞的植物学特性及其应用. 贵州畜牧兽医, 2009, 33(6):45-46. |
| [14] | 杨玺文, 张燕, 李隆云. 药用植物金荞研究进展. 中国现代中药, 2019, 21(6):837-846. |
| [15] |
李钰莹, 刘娜, 荆则尧, 等. 黄花蒿浸提液对4种草坪草种子萌发及幼苗生长的影响. 草地学报, 2020, 28(5):1285-1293.
doi: 10.11733/j.issn.1007-0435.2020.05.013 |
| [16] | 宋越冬, 陈晓庆, 张毓敏, 等. 荞麦叶黄酮的提取工艺优化及其抗氧化性. 食品工业科技, 2021, 42(7):180-187. |
| [17] |
李善魁, 孟焕文, 李宇晨, 等. 圆柏对几种农田杂草及作物的化感潜力分析. 草地学报, 2021, 29(8):1769-1778.
doi: 10.11733/j.issn.1007-0435.2021.08.020 |
| [18] | 孔庆博, 杨帅, 王小菊, 等. 巨尾桉精油对黑麦草、小麦种子的化感作用研究. 四川农业大学学报, 2021, 39(6):713-720. |
| [19] | 杨莉, 王春雨, 王菡, 等. 加拿大蓬挥发油化感作用及其释放途径的研究. 西北植物学报, 2010, 30(10):2116-2122. |
| [20] | 肖薪龙, 张晨, 丁海燕, 等. 利用两种溶剂浸提探究苦荞各部分化感效应. 西北农业学报, 2011, 20(1):153-158. |
| [21] |
马光宗, 杨云海, 徐高峰, 等. 苦荞提取物的化感作用及化学成分分析. 中国农学通报, 2021, 37(34):112-120.
doi: 10.11924/j.issn.1000-6850.casb2021-0785 |
| [22] | 包塔娜, 周正质, 张帆, 等. 苦荞麦麸皮的化学成分研究. 天然产物研究与开发, 2003(2):116-117. |
| [23] |
Kim S J, Maeda T, Sarker M Z I, et al. Identification of anthocyanins in the sprouts of buckwheat. Journal of Agricultural and Food Chemistry, 2007, 55(15):6314-6318.
doi: 10.1021/jf0704716 |
| [24] | 徐宝才, 肖刚, 丁霄霖. 色谱法分析检测苦荞籽粒中的可溶性糖(醇). 色谱, 2003(4):410-413. |
| [25] |
Chon S U, Jang H G, Kim D K, et al. Allelopathic potential in lettuce (Lactuca sativa L.) plants. Scientia Horticulturae, 2005, 106(3):309-317.
doi: 10.1016/j.scienta.2005.04.005 |
| [26] | 林娟, 殷全玉, 杨丙钊, 等. 植物化感作用研究进展. 中国农学通报, 2007(1):68-72. |
| [1] | 王宇, 王金生, 王晓曦, 马力, 王克勤, 王春, 刘兴龙, 吴俊江, 李沐恺. 玉―豆和麦―豆轮作对大豆田杂草发生规律的影响[J]. 作物杂志, 2026, (1): 175–181 |
| [2] | 龙卫华, 咸志慧, 张正, 阿里别里根·哈孜太, 祖勒胡玛尔·乌斯满江, 浦惠明, 胡茂龙. 长江下游非转基因抗除草剂杂交油菜品系在新疆伊犁河谷的适应性分析[J]. 作物杂志, 2025, (1): 111–116 |
| [3] | 于乐, 李林, 黄红娟, 黄兆峰, 朱文达, 魏守辉. 湖北省玉米田杂草种类组成及群落特征[J]. 作物杂志, 2023, (5): 272–279 |
| [4] | 杨世奇, 陈丽明, 周燕芝, 谭雪明, 曾勇军, 石庆华, 潘晓华, 曾研华. 杂草防除对双季直播优质晚籼稻产量和稻米品质的影响[J]. 作物杂志, 2023, (2): 121–125 |
| [5] | 李秉华, 王贵启, 师志刚, 刘小民, 许贤, 赵铂锤, 程汝宏. 谷子和杂草对氰氟草酯的敏感性[J]. 作物杂志, 2022, (4): 262–266 |
| [6] | 王芙蓉, 张建学, 郭岷江, 张亚宏, 范提平, 王亚宏, 张岩, 裴国平, 雷建明. 苗后除草剂喷施时期对杂草防治及冬油菜产量和品质的影响[J]. 作物杂志, 2020, (5): 204–208 |
| [7] | 陈叶,南静,苏彩娟,马银山,魏宁,景玉霞. 膜荚黄芪根水浸液对4种作物种子萌发及幼苗生长的影响[J]. 作物杂志, 2020, (2): 188–193 |
| [8] | 周燕芝,王文霞,陈丽明,曾勇军,谭雪明,胡水秀,石庆华,潘晓华,曾研华. 直播稻田杂草发生与防除研究进展[J]. 作物杂志, 2019, (4): 1–9 |
| [9] | 穆云森,温晓蕾,杨燕萍,刘欣欣,郭娟,崔敬,宋楠,左学丽,车永和. 新疆杂草黑麦基本农艺性状分析[J]. 作物杂志, 2019, (4): 42–48 |
| [10] | 刘亚军,储凤丽,王文静,胡启国,杨爱梅. 不同配套栽培措施对商薯9号产量及杂草防控的影响[J]. 作物杂志, 2019, (2): 179–184 |
| [11] | 李悦,李海燕,于吉东,邓杰,宫远福,朱俊澍. 线麻秸秆浸提液对大豆的化感作用[J]. 作物杂志, 2019, (1): 175–179 |
| [12] | 张建华,郭瑞峰,曹昌林,范娜,江佰阳,李光,史丽娟,彭之东,白文斌. 几种茎叶除草剂防除高粱田杂草药效和安全性研究[J]. 作物杂志, 2018, (5): 162–166 |
| [13] | 赵存虎,孔庆全,陈文晋,贺小勇,田晓燕. 蚕豆田除草剂筛选初报[J]. 作物杂志, 2018, (5): 167–172 |
| [14] | 宋敏,张海鹏,路兴涛,吴翠霞,张勇. 不同除草剂对冬小麦田宝盖草的防除效果[J]. 作物杂志, 2018, (2): 161–165 |
| [15] | 李燕敏,祁显涛,刘昌林,刘方,谢传晓. 除草剂抗性农作物育种研究进展[J]. 作物杂志, 2017, (2): 1–6 |
|
||